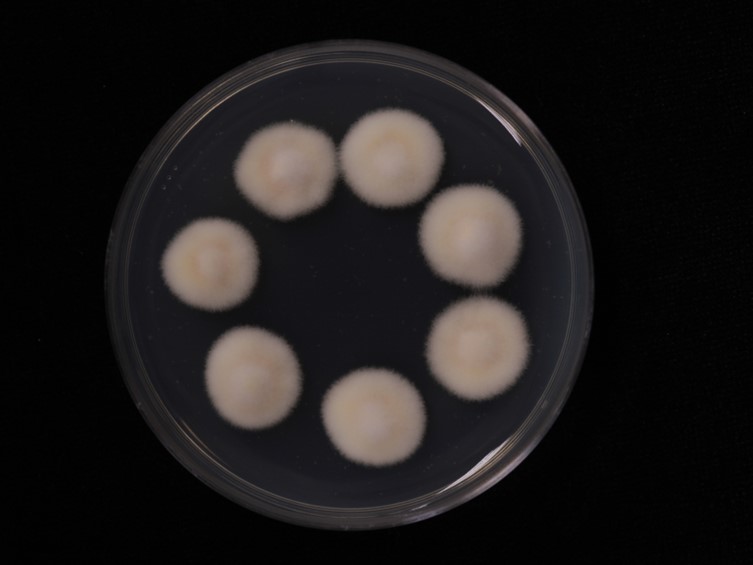

Holotype:
THAILAND, Chiang Mai Province, Ban Hua Thung Community Forest, 25 Oct. 2013, K. Tasanathai, P. Srikitikulchai, A. Khonsanit, W. Noisripoom, D. Thanakitpipattana, S. Watcharapayungkit, holotype BBH 38731, ex-type living culture BCC 68398.
Habitat:
Leaf litter.
Host:
Pupa of Odontomachussp.
Description:
 Stromata simple or compound, cylindrical, light orange, flexuose, arising from the sides of the ant pupae, 3-7 × 0.5-1 mm.
Stromata simple or compound, cylindrical, light orange, flexuose, arising from the sides of the ant pupae, 3-7 × 0.5-1 mm. 








 Terminal part of the stroma fertile, cylindrical to obovoid.
Terminal part of the stroma fertile, cylindrical to obovoid.  Perithecia superficial, narrowly ovoid to obclavate, 200-300 × 70- 120 μm. Asci cylindrical, 8-spores, 150-200 × 3-5 μm. Ascospores whole, bola-shaped, 200-250 μm in length, central part filiform, terminal parts narrowly fusiform, 25-38 × 1 μm, three septa.
Perithecia superficial, narrowly ovoid to obclavate, 200-300 × 70- 120 μm. Asci cylindrical, 8-spores, 150-200 × 3-5 μm. Ascospores whole, bola-shaped, 200-250 μm in length, central part filiform, terminal parts narrowly fusiform, 25-38 × 1 μm, three septa.
Culture characteristics:
Colonies on PDA are relatively fast-growing, attaining a diam of 10 mm in 7 d at 22 °C. Colonies at first white, becoming pale orange or brownish orange. Reverse orange to light brown. Mariannaea and, less commonly, evlachovaea-like conidial morphs developing after ca 10 d. Colony at first velvety, becoming funiculose in the colony center with age.
Colonies on PDA are relatively fast-growing, attaining a diam of 10 mm in 7 d at 22 °C. Colonies at first white, becoming pale orange or brownish orange. Reverse orange to light brown. Mariannaea and, less commonly, evlachovaea-like conidial morphs developing after ca 10 d. Colony at first velvety, becoming funiculose in the colony center with age.  Conidia at first fusoid, then elongating and becoming cylindrical with age, hyaline, smooth-walled, 4–12 × 1–2 μm, ends rounded.
Conidia at first fusoid, then elongating and becoming cylindrical with age, hyaline, smooth-walled, 4–12 × 1–2 μm, ends rounded.  Phialides cylindrical with tapering ends, smooth-walled, 16–20 × 2–3 μm.
Phialides cylindrical with tapering ends, smooth-walled, 16–20 × 2–3 μm.
Reference:
Tasanathai K, Thanakitpipattana D, Noisripoom W, et al. (2016). Two new Cordyceps species from a community forest in Thailand. Mycological Progress 15: 28.
DOI: http://doi.org/10.1007/s11557-016-1170-3Species |
Strain |
Compound |
Pubchem CID |
Biological activity |
Reference |
|---|
|
Strain |
ITS | TEF1 |
|---|---|---|
| BCC 55820 | KT261389 | KT261399 |
| BCC 55830 | KT261390 | KT261400 |
| BCC 55831 | KT261391 | KT261401 |
| BCC 68398 | KT261388 | KT261398 |
| BCC 68403 | KT261392 | KT261402 |